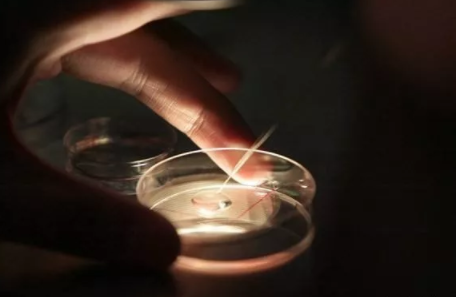
QQ圖片20191212101906.png

很多做泰國試管嬰兒的夫妻都有這樣的疑問:為什么同樣是泰國試管嬰兒促排,我的方案和別人不一樣呢?為什么別人已經取卵,我卻還在促排呢?為什么她用的短方案,我用的長方案呢?
今天就和大家相信的說一說促排方案這些事。
在試管嬰兒治療過程中,為了獲得更多成熟的卵子,女方需要使用促排卵藥物。促排方案有長方案、短方案、超長方案等,選擇了不同的方案,治療周期也會有所不同,為大家詳細的介紹一下。
首先,每種方案都是有適應的癥狀,簡單地說就是:醫生會根據的情況來定方案。
超長方案到底有多長
超長方案顧名思義是促排方案中較長的,這讓很多女性朋友著實嚇了一跳,超長方案到底有多長呢?在眾多促排卵方案中,是耗時較長的,約兩個月。
超長方案主要適用于子宮內膜異位癥、子宮腺肌癥,也可應用于多囊卵巢綜合征、高LH血癥、反復種植失敗。超長方案需要的時間較長方案多1個月的時間,需要注射2次降調節藥物,兩次之間需間隔1個月。
具體流程
一:月經來潮第2~4天肌肉注射長效降調藥物。
二:28~30天后再次注射,連續注射2~3支。
三:末次注射后28~30天監測激素水平和超聲,達到降調節標準后啟動促排。
四:促排卵過程與長方案相同。
泰國試管嬰兒促排長方案
長方案:主要適用于情況比較理想,卵巢儲備功能正常的。雖然時間略長,但比其他方案促排效果佳。因此,是促排卵方案中常用方案之一。
具體流程
一.月經來潮的第2至5天,做陰道B超檢查基礎卵泡(數量)并檢查性激素6項(質量)。
二.月經來潮的第18至22天,B超檢查大卵泡是否已經排出,孕酮是否已經升高,然后確定降調節時間。
三.降調第14天開始使用促性腺激素FSH或HMG進行促排卵,一般注射10天左右,注射較后一針促排卵藥物的當天晚上需注射HCG(俗稱打夜針),后36小時取卵。
泰國試管嬰兒促排短方案
該方案適用于年齡大、卵巢功能不良的。顧名思義,短方案所需要的時間較短,前后約需10-15天時間。從月經周期第2或第3天開始用降調,同時進行促性腺激素注射,一直到夜針日。
泰國試管嬰兒促排拮抗劑方案
持續時間與短方案相似,主要適用人群與短方案相同,除此之外尤其適用于多囊卵巢綜合征的,該方案可以大大減少多囊卵巢綜合癥的出現卵巢過度刺激的風險。
歐洲人類生殖與胚胎學會關于預防卵巢過度刺激綜合癥(OHSS)發生的指南指出,對于年齡小于35歲和OHSS高風險的推薦首選拮抗劑方案。該方案是從月經周期第2或第3天開始用促性腺激素,在卵泡長大到14mm左右時或雌激素明顯上升時,同時使用拮抗劑,至夜針日。
泰國試管嬰兒促排微刺激方案
與常規刺激方案相比使用劑量較低,促排時間也較短。此方案常用于卵巢低反應,也可用于卵巢過度刺激綜合癥高風險的高反應人群和有激素依賴腫瘤風險的。
醫生會根據月經期的卵巢情況及性激素水平判斷如何用藥,一般是從月經周期第2或第3天開始口服促排藥物,期間或5天后進行促性腺激素注射至夜針日。
泰國試管嬰兒促排自然周期
該方案是不用任何藥物刺激卵巢誘導排卵,但必須通過臨近排卵期反復監測LH峰估計排卵時間,以便獲取成熟卵細胞。
自然周期的獲卵率相對較低,其較大的優點是簡單經濟,可重復性強,不存在卵巢過度刺激和多胎妊娠的風險。主要用于自愿選擇自然周期、卵巢低反應以及因存在一些疾病風險不能進行卵巢刺激的。
對于想做泰國試管嬰兒的家庭肯定好奇自己到底應該選擇什么促排方案,其實完全不用擔憂,醫生會根據女性不同病史、卵巢情況及個人特點,進行方案的選擇和調整,已達到較終受孕的目的。

